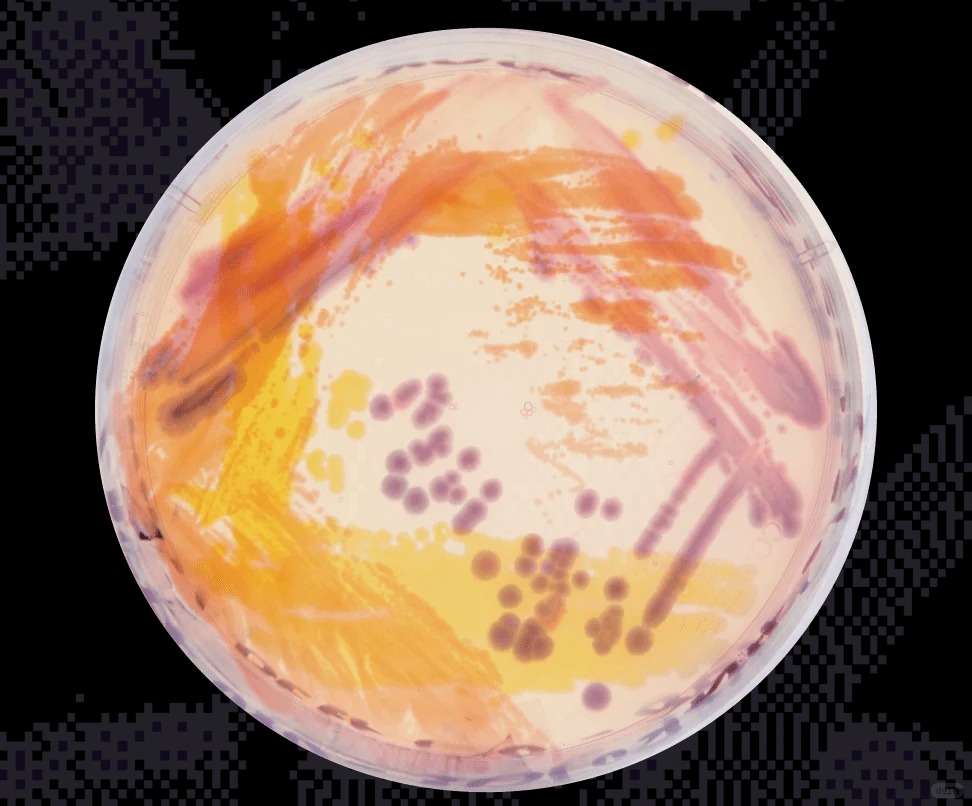

RCA IDE作品分享 |Suche
发布时间:2025-12-02 11:40 | 点赞:8 | 浏览:3135
Suche 是Juan在 合成生物学 × 微生物学 × 纺织设计 交叉领域进行的研究。
Juan探索如何利用细 菌 可持续生产天然染料(类胡萝卜素、吲哚色素),以替代传统高污染染料。
项目以“地点性”为核心方法,尝试借助哥伦比亚的生物多样性重新振兴当地停滞的纺织产业。

点赞
收藏
注:本站上发表的所有内容,均为原作者的观点,不代表艺集网的立场,也不代表艺集网的价值判断。如有版权纠纷,请联系艺集网。
# 艺术设计
推荐作品

Hanko Ruler  暮色
暮色
工业/产品
葡萄酒食品品牌植物插图酒瓶标签包装设计  染指徒留
染指徒留
平面设计





